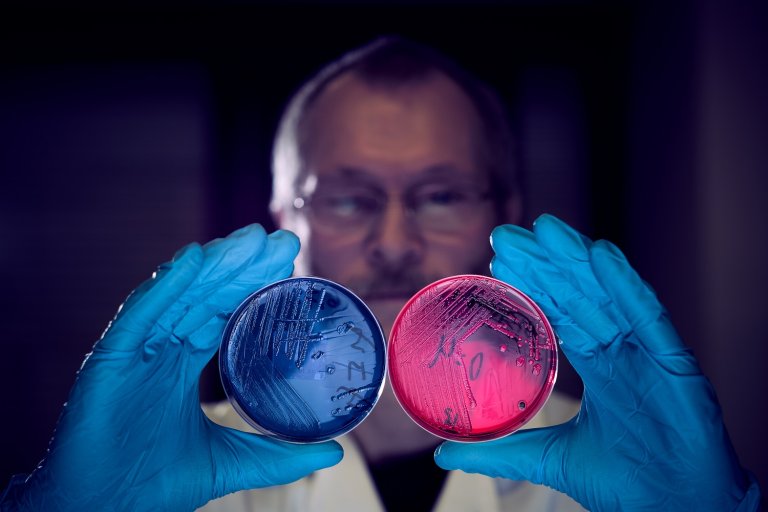
Forsker som holder opp to petriskåler foran kamera

Veterinærinstituttet nytt medlem i europeisk ekspertkomité for kategorisering av antibiotikaresistente bakterier hos dyr
Veterinærinstituttet er nytt medlem av VetCAST, en europeisk ekspertkomité som setter grenseverdier for når ulike bakterier hos dyr kan kategoriseres som følsomme eller resistente mot antibiotika.
-Globalt øker forekomsten av antibiotikaresistente bakterier fra dyr. Riktig bruk av antibiotika er viktig for å bremse denne utviklingen. For å kunne velge riktig antibiotika må man vite om bakterien det skal behandles mot er resistent eller ikke. Her har VetCAST en viktig funksjon i å sette grenseverdier for når ulike bakterier hos dyr kan kategoriseres som følsomme eller resistente overfor antibiotika, sier Marit Gaastra Maaland, forsker ved Veterinærinstituttet.
Ekspertkomitéen Veterinary Committee on Antimicrobial Susceptibility Testing (VetCAST) ble opprettet i 2015 og er en undergruppe av the European Committee on Antimicrobial Susceptibility Testing (EUCAST)
Bakgrunnen for opprettelsen av VetCAST er mangelen på såkalte brytningspunkter («breakpoints») for bakterier fra dyr.
Når er en bakterie resistent?
Brytningspunkter er punktene som beskriver når en bakterie går fra å være fullt følsom for antibiotika til å bli mer og mer resistent mot antibiotika. Et brytningspunkt kan for eksempel være det punktet når en bakterie går fra å være følsom for antibiotika til at den er moderat resistent.
Ifølge Gaastra Maaland, skal brytningspunkter ideelt sett være basert på en kombinasjon av mikrobiologiske, farmakologiske og kliniske data fra den aktuelle bakterie- og dyrearten.
Men i virkeligheten mangler ofte slike data for bakterier fra dyr, og man anvender derfor ofte brytningspunkter for bakterier fra mennesker i stedet.
-Mangelen på spesifikke brytningspunkter for bakterier fra dyr kan føre til feiltolkning slik at en bakterie klassifiseres som følsom når den i virkeligheten er resistent, eller vice versa. Dette kan videre føre til feilaktig bruk av antibiotika, feilbehandling og ytterligere utvikling av antibiotikaresistens, sier Gaastra Maaland.
Dette er VetCAST
VetCAST er en ekspertkomité under EUCAST. EUCAST ble opprettet i 1997 med formål om å definere og harmonisere antibiotika følsomhetstesting og humane brytningspunkter i Europa.
EUCAST organiseres av European Society of Clinical Microbiology and Infectious Diseases (ECCMID), European Centre for Disease Prevention and Control (ECDC) og europeiske, nasjonale komiteer for brytningspunkter. EUCAST definerer brytningspunkter for European Medicines Agency (EMA) og ECDC.
I VetCAST er det 50 medlemmer (veterinære mikrobiologer, farmakologer og klinikere) fra 13 forskjellige europeiske land, Marit G. Maaland fra Veterinærinstituttet er nylig blitt med som en av disse ekspertene.
Formålet med VetCAST er å etablere brytningspunkter som er spesifikke for bakterier fra forskjellige dyrearter, for derved å bidra til korrekt og rasjonell bruk av antibiotika.
VetCAST ønsker utover dette å initiere og koordinere EU-forskning med mål om å fylle kunnskapshull innenfor veterinær antibiotika følsomhetstesting, bidra til en harmonisering av følsomhetstesting av sykdomsfremkallende bakterier hos dyr i Europa, samt å undervise og veilede i bruk av følsomhetstesting og behandling med antibiotika innen det veterinære fagområdet.
VetCAST har nylig publisert en uttalelse som forklarer hvordan komiteen går frem for å definere veterinære brytningspunkter. Les uttalelsen under «Publications» på EUCAST sine nettsider